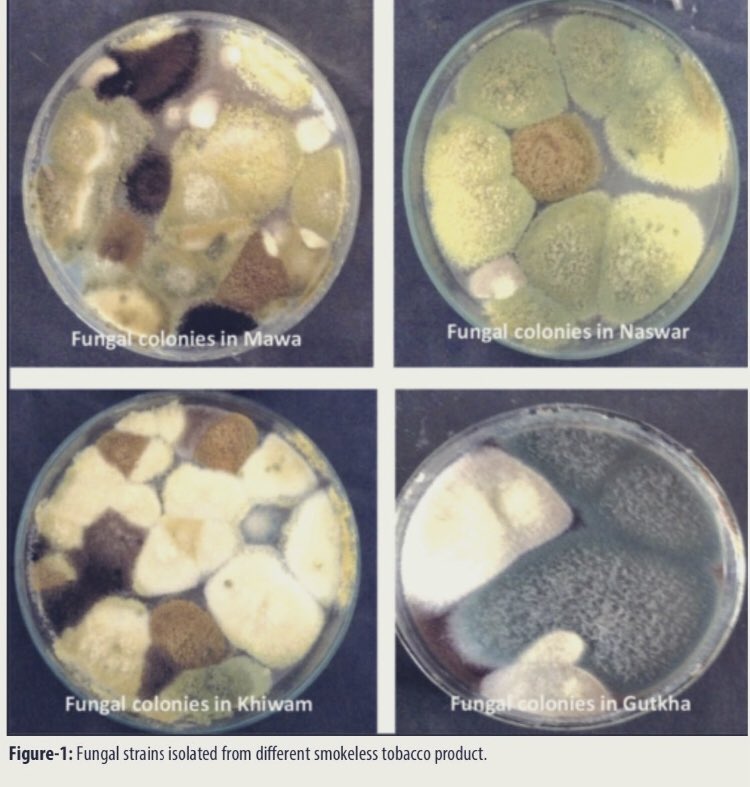

أكدت الدراسات التي أجريت على الشمة أنها تحتوي على مواد #سامة ، كما انها تحتوي مادة الشمة على مطفرات وراِثية تسبب مرض السرطان، وأن نسبة عالية جداً من مرضى سرطان الفم كانوا يتعاطون هذه المادة.
ليس فقط يسبب الالتهابات الفطرية?? بين المستهلكين ، ولكن يمكن أيضا تسبب السموم الفطرية بسبب استهلاك مثل هذه المنتجات الملوثة بالسموم الفطرية التي تنتجها الفطريات مثل الأفلاتوكسين وقد تم تأكيد وجوده في المنتجات .
جاري تحميل الاقتراحات...